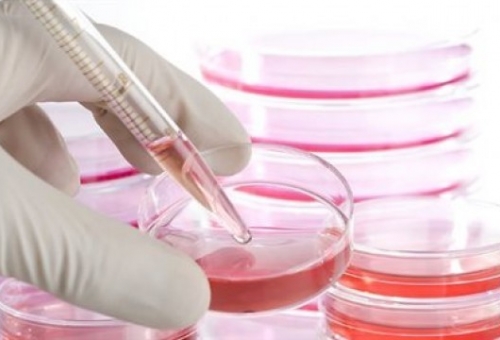
Νέα πιο αποτελεσματική μέθοδος δημιουργίας βλαστικών κυττάρων

Super User
Καταβολή αποζημιώσεων στους πυρόπληκτους της Πελοποννήσου
Ξεκίνησε τη Δευτέρα 15/9 στην Τρίπολη η καταβολή της δωρεάν κρατικής αρωγής στους πληγέντες δικαιούχους του νομού Αρκαδίας, από τις...
ΠΕΡΙΣΣΟΤΕΡΑ
Δρομολογείται η εμπορική συνεργασία Ελλάδας-Κένυας
Στόχος η προώθηση των τοπικών προϊόντων της Λακωνίας
ΠΕΡΙΣΣΟΤΕΡΑ
Πώς να φτιάξεις σπιτικά πίλινγκ σώματος κατά της κυτταρίτιδας
Επιμέλεια: Βάσια Σταυροπούλου
ΠΕΡΙΣΣΟΤΕΡΑ
Νέα πιο αποτελεσματική μέθοδος δημιουργίας βλαστικών κυττάρων
Μια νέα μέθοδο επαναπρογραμματισμού ενηλίκων βλαστικών κυττάρων ώστε να επανέρχονται στην αρχέγονη κατάστασή τους παρουσίασαν αμερικανοί επιστήμονες, σύμφωνα με στοιχεία...
ΠΕΡΙΣΣΟΤΕΡΑ
Το ζώο της εβδομάδας: Λιβελλούλα (Τάξη Οδοντόγναθα )
Τo ζώο της τρέχουσας εβδομάδας είναι ένα από τα περισσότερο δημοφιλή και «αποδεκτά» έντομα, σε αντίθεση με την πλειονότητα των...
ΠΕΡΙΣΣΟΤΕΡΑ

18/09/2014

18/09/2014